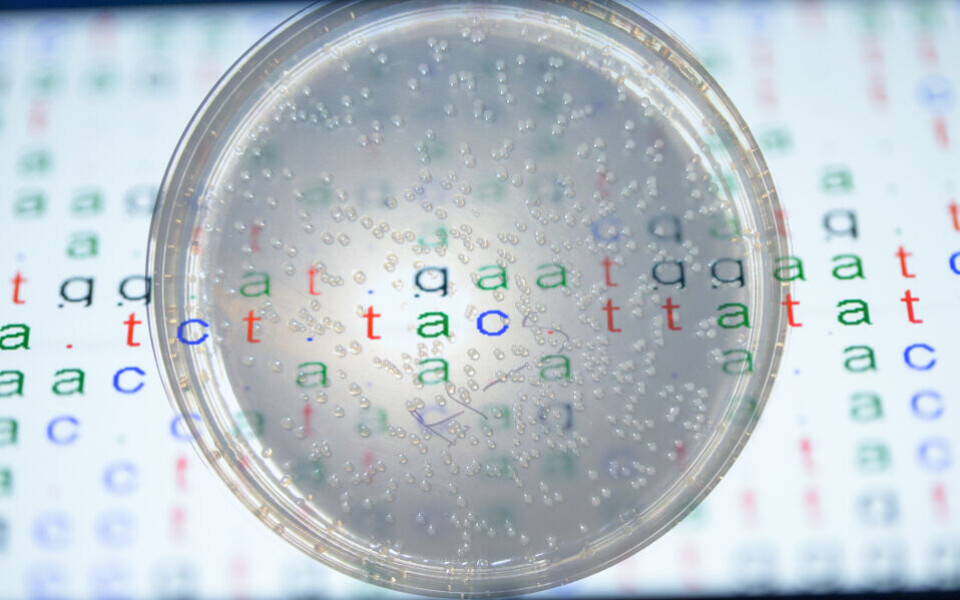

FAG Aktuelt
Dyrking i skål forsvinner ikke med det første
Det er en lang vei å gå før fenotypisk resistensbestemmelse kan erstattes av genteknologiske metoder.
Det mener Ørjan Samuelsen, forsker ved Nasjonal kompetansetjeneste for påvisning av antibiotikaresistens (K-res).
Genomsekvensering blir stadig billigere og kjappere. Samtidig er det stigende behov for hurtig mikrobiologisk diagnostikk, på grunn av økende forekomst av antibiotikaresistens. Rask resistenstesting bidrar til at pasientene snarest mulig får rett antibiotika, som bakteriene er følsomme for. Det kan også bidra til mer bruk av smalspektrede antibiotika, som gir mindre resistensutvikling.
Sekvensering har stort potensiale
- Potensialet til helgenomsekvensering er å kunne predikere følsomhet eller resistens i én enkelt test. I tillegg kan sekvenseringsdataene brukes til å identifisere bakterier og virulensfaktorer, epidemiologisk overvåkning og kartlegging av utbrudd, sier Samuelsen.
Han er med i en underkomité i EUCAST (European Committee on Antimicrobial Susceptibility Testing) som har lagd en rapport om bruk av helgenomsekvensering for resistenstesting. Rapporten ble nylig publisert i tidsskriftet «Clinical Microbiology and Infection». Helgenomsekvensering kan bli en revolusjon innen mikrobiologisk diagnostikk, skriver forfattergruppen.

Men spør man om genomsekvensering nå kan erstatte fenotypisk resistenstesting er svaret, ifølge Samuelsen, inntil videre nei.
Resistens forårsakes av mange egenskaper
- En av utfordringene er at bakteriers følsomhet for antibiotika kan avhenge av flere faktorer enn kun tilstedeværelse eller fravær av resistensgener, sier han.
Det er ikke uvanlig at bakterier har resistensgener mot bestemte typer antibiotika, men likevel viser seg å være følsomme. For eksempel har mange Enterobacteriaceae gener for karbapenemase-produksjon, men er likevel ikke resistente mot det bredspektrede karbapenemet meropenem.
Når bioingeniører undersøker bakteriers resistensprofil, kan det ligge et komplekst samspill mellom flere resistensmekanismer bak resultatet som leses av i skålen.
- For eksempel kan betalaktamresistens hos Gram negative bakterier skyldes en kombinasjon av utpumping av antibiotika (effluks), egenskaper som bryter ned antibiotika og egenskaper som stopper antibiotika fra å komme inn gjennom celleveggen. Opp- og ned-regulering av genuttrykk kan avgjøre hvilke egenskaper som aktiveres. Slike endringer kan ikke leses ut fra DNA-sekvensen, påpeker Samuelsen.
Raskere svar for tuberkulose
Han forteller at det er gjort studier som viser godt samsvar mellom genotypi og fenotypi for Staphylococcus aureus. Dette er én av artene hvor overvåkning av resistens kan skje med genomsekvensering i stedet for fenotypisk testing, ifølge EUCAST-rapporten.
Samuelsen mener at tuberkulosediagnostikk er det feltet hvor genomsekvensering først vil få direkte betydning for pasientbehandlingen. Det tar lang tid å dyrke M. tuberculosis. I én studie fikk man resistenssvar fra helgenomsekvensering hele 21 dager tidligere enn med tradisjonell metode.
Forutsetninger for klinisk nytte
- Forståelsen av mekanismene bak antibiotikaresistens må bli større før resistensbestemmelse med genomsekvensering kan bli utbredt i den kliniske hverdagen. For mange arter kreves mye sterkere samsvar mellom genotypi og fenotypi, sier Samuelsen.
EUCAST-rapporten peker også på flere andre faktorer som gjør at den genetiske revolusjonen ikke er rett rundt hjørnet:
- Per i dag fines det ikke en kontinuerlig oppdatert og standardisert database over resistensgener.
- Det mangler internasjonalt aksepterte kriterier for kvalitetskontroll av sekvensdata.
- Man må utvikle bedre bioinformatiske verktøy for å ha klinisk nytte av sekvenseringsdata.
- Sekvenseringsteknologien bør bli enda billigere og raskere.
Kilder:
- “The role of whole genome sequencing in antimicrobial susceptibility testing of bacteria, report from EUCAST Subcommittee” i “Clinical Microbiology and Infection” 23 (2017) 2 – 22.
- Foredrag av Ørjan Samuelsen på årsmøtet til The Nordic Society of Clinical Microbiology and Infectious Diseases (sept. 2016): “Genotypic antimicrobial susceptibility testing (AST) – the use of whole genome sequencing (WGS)”.
- Universitetssykehuset Nord-Norge: unn.no/fag-og-forskning/k-res
Temaside om antibiotikaresistens